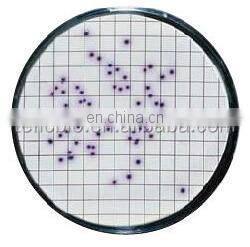
0.45um Microporous Sterile MCE Membrane Filter Grid for LAB

Microporous Solvent Millipore Nylon Membrane Filter
The microporous membrane filter is mainly used for the filtration of mobile phase and samples during the chromatographic annlysis, especially for preventing chromatographic column and infusion pimp line system
and sample valve from pollution. They are widely used for gravimetric analysis,microanalysis, colloid separation
and sterility test. The filter membrane made of different materials, such as polyetherdulfone(PES), nylon6,
Nylon66, MCE and polytetrafluoroethylene(PTFE), PVDF etc. can be provide.
How to choose right microporous membrane filter?
NYLON66
High quality nylon66 membrane are suitable for filtering aqueous solution and most arganic solvents. The menbrane are suitable for use with a wide range of biological preparations and can be used where other membrane are unsuitable or difficult to use.Nylon66 membrane are hydrophilic, eliminating the need for wetting agents thae could be extracted when filtering aqueous solutions. The membrane are flexible, duable and tear resistant, and can be autoclaved at 121℃. | ![]() |
PTFE
![]() | PTFE is the membrane of choice for use with the aggressive solveents, liquids and gas sterilization. Hydrophilic PTFE can be used to filter aqueous and organic mixed liquids. |
Mixed Cellilose Ester(MCE)
MCE membrane filters aremodified to offer researchers the lowest binding filters available. Due to the extremely low binding characteristics, these filters provide higher throughputs than competitive offerings and redece filter changes when filtering. | ![]() |
Hydrophplic PVDF
![]() | Used in applications such as multi-plexed bead-based assays, the filtration of dilute protein samoles, cold and hot water for injection(WFI), chemicals, aggressive solvents and sanitizing agents, Not suitable for acetone, DMSO, or based>6N. |
PES
| Polyethersulfone(PES) membrane are hydrophilic, low protein blinding and stable in alkaline PH. Available in a 0.8um pore size, the PES membrane is recommended for aqueous applications and for biological samples. They are also an alternative choice for users requiring a filter that sxhibits extremely low protein binding chaacteristics. This kind of membrane is imported from MEMBRANE company Germany. | ![]() |
We also provide PP filter, Glass fiber , Quartz fiber, Polycarbonate filters ect
Applications
| Material | Pore Size(um) | Diameter(mm) | package |
| Nylon66 | 0.1, 0.22, 0.45,0.65, 0.8, 1.0, 1.2, 3, 5 | 13,25, 47, 50,60,90 100, 125, 150, 200 other size is available | 100pcs/ pack |
| PTFE | 0.1, 0.22, 0.45,0.65, 0.8, 1, 2, 3, 5 | 13,25, 47, 50,60,90 100, 125, 150, 200 other size is available | 100pcs/ pack |
| MCE | 0.1, 0.22, 0.3, 0.45,0.65, 0.8, 1.0, 1.2, 3, 5 ,8 | 13,25, 47, 50,60,90 100, 125, 150, 200 other size is available | 100pcs/ pack |
| PVDF | 0.1, 0.22, 0.45,0.65, 0.8, 1, 2, 3, 5 | 13,25, 47, 50,60,90 100, 125, 150, 200 other size is available | 100pcs/ pack |
| PES | 0.05, 0.1, 0.22, 0.45,0.65, 0.8, 1, 2, 3, 5 ,8, 10 | 13,25, 47, 50,60,90 100, 125, 150, 200 other size is available | 100pcs/ pack |
| PP | 0.1, 0.22, 0.45,0.65, 0.8, 1.2, 3, 5 ,8, 10 | 13,25, 47, 50,60,90 100, 125, 150, 200 other size is available | 100pcs/ pack |
| Glass fiber | 0.22, 0.45,0.7, 1.0, 1.2, 1.6, 1.7 | 13,25, 47, 50,60,90 100, 125, 150, 200 other size is available | 50pcs/ pack |
| Quartz fiber | 2(for PM2.5) | 47, 50 ,90 | 50pcs/ pack |
| Polycarbonate | All Size | All size | 50pcs/ pack |
Sterile Membrane Filter
Single packed sterile membrane can be used for colony counting, partice testing,microscopy and sterilty testing.
The menbrane filters are made of MCE, PES, CA,RC oe Nylon, chose between gridded or non-gridded. Among
all these material, MCE is the most common type .Sterile MCE is a mixture of nitrocellulose and cellulose acetate.

Application
1. Ideal for capturing and culturing microorganisms in the Water and wastewater industry.
2. Used to determine particulate contamination of lubricating oil and hydraulic fluid in
patch test kits
Product Name | Pore Size(um) | Diameter(mm) | Package |
| MCE White Gridded | 0.45 | 47 | 200pcs/pack |
| MCE Black Gridded | 0.45 | 47 | 200pcs/pack |
Related Product
Syingle Filter
Nylon66 PES PTFE PVDF
Packaging & Shipping
1.Storage:Store at room temperature under dry environment
2.Shelf life:Five years under well Storage situation
3.Conventional Package: Color innerbox+ Waterproof Bubble Wrap+ Carton

How to Contact Us?
Give us your raw material,your master (general plot) plan,your capacity,your budget,and your other requirement.
Send your Inquiry Details in the Below, Click "Send" Now!
Send Inquiry to This Supplier
You May Also Like
-
Cleam Room Air ShowerNegotiableMOQ: 1 Set
-
Genyond Glass Bottle Washer for LabNegotiableMOQ: 1
-
Microwave Chemical ReactorUS$ 1500 - 1750MOQ: 1 Piece
-
Laboratory 10ml/25ml/50ml/100ml Glass Colorimeter TubeUS$ 11.48 - 18.28MOQ: 100 Pieces
-
GC-9801 Gas Chromatography Machine for LabUS$ 7,000 - 10,000MOQ: 1 Set
-
Cheapest Price Hospital Lab Equipment Vacuum Dryer CabinetNegotiableMOQ: 1 Set
-
School Laboratory Furniture Stainless Steel Sink Laboratory pp Sink Supplier's ChoiceUS$ 16 - 50MOQ: 1 Set
-
High Quality Competitive Price Medicine Spoon / Spatula / Plastic Spoon With Long Handle Used in Chemistry LaboratoryUS$ 3 - 10MOQ: 1 Piece
-
Gas Chromatography With FID Detector for Residual SolventUS$ 7,000 - 10,000MOQ: 1 Set
-
Standard Cryogenic Bulk Storage Tanks/cryogenic Standard Tanks/cryogenic Storage TanksUS$ 21,790 - 28,000MOQ: 1 Piece